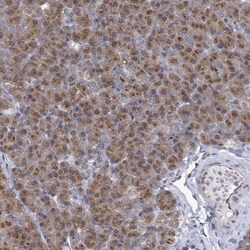
Invitrogen ARFGAP1 Polyclonal Antibody 100 &mu;L; Unconjugated:Antibodies,

missing translation for 'onlineSavingsMsg'
Learn More
Learn More
Invitrogen™ ARFGAP1 Polyclonal Antibody
Rabbit Polyclonal Antibody
Brand: Invitrogen™ PA584044
This item is not returnable.
View return policy
Description
Immunogen sequence: DHFQNSNIDQ SFWETFGSAE PTKTRKSPSS DSWTCADTST ERRSSDSWEV WGSASTNRNS NSDGGEGGEG TKKAVPPAVP TDDGWD Highest antigen sequence indentity to the following orthologs: Mouse - 69%, Rat - 67%.
ArfGAP1 is a 406 amino acid containing regulatory protein with an Arf-GAP domain known to be involved in the activation of the GTPase activity of ADP ribosylation factor (ARF). ArfGAP1, a GTPase-activating protein (GAP) for the ADP ribosylation factor 1 (ARF1), promotes the hydrolysis of ARF1-bound GTP and is required for the dissociation of coat proteins from Golgi-derived membranes and vesicles thus playing an important role in membrane trafficking and/or vesicle transport. Dissociation of the coat proteins is required for the fusion of these vesicles with target compartments. The activity of this protein is stimulated by phosphoinosides and inhibited by phosphatidylcholine. Two transcript variants encoding different isoforms have been reported. Ubiquitous expression of ArfGAP1 is seen in most tissues.
Specifications
| ARFGAP1 | |
| Polyclonal | |
| Unconjugated | |
| ARFGAP1 | |
| ADP ribosylation factor GTPase activating protein 1; ADP-ribosylation factor 1 GTPase activating protein; ADP-ribosylation factor 1 GTPase-activating protein; ADP-ribosylation factor GTPase activating protein 1; ADP-ribosylation factor GTPase-activating protein 1; AI115377; ARF GAP 1; Arf GAP1; ARF1 GAP; ARF1-directed GTPase-activating protein; Arf1gap; ARFGAP1; EGK_02194; GAP protein; HRIHFB2281; RP11-261N11.1 | |
| Rabbit | |
| Antigen affinity chromatography | |
| RUO | |
| 55738 | |
| Store at 4°C short term. For long term storage, store at -20°C, avoiding freeze/thaw cycles. | |
| Liquid |
| Immunohistochemistry (Paraffin), Western Blot, Immunocytochemistry, Western Blot | |
| 0.2 mg/mL | |
| PBS with 40% glycerol and 0.02% sodium azide; pH 7.2 | |
| Q8N6T3 | |
| ARFGAP1 | |
| Recombinant protein corresponding to Human ARFGAP1. Recombinant protein control fragment (Product #RP-99305). | |
| 100 μL | |
| Primary | |
| Human | |
| Antibody | |
| IgG |
Product Content Correction
Your input is important to us. Please complete this form to provide feedback related to the content on this product.
Product Title
Spot an opportunity for improvement?Share a Content Correction